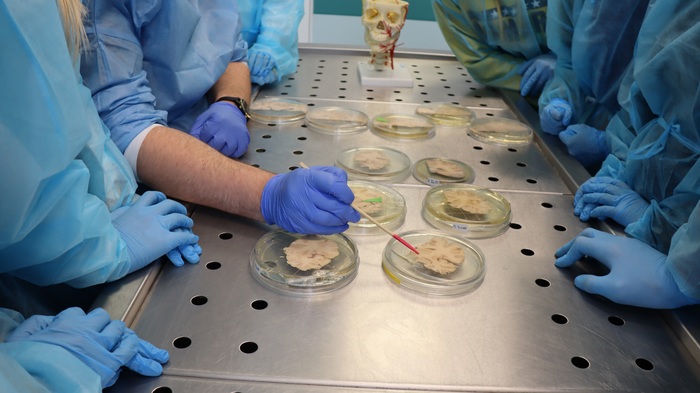

Licealiści odświeżyli wiedzę z anatomii
12.04.2022
Za nami kolejne spotkanie z uczestnikami projektu Nauka to ludzie. Tym razem uczniowie goszczący 9 i 10 kwietnia 2022 r. w Gdańskim Uniwersytecie Medycznym odwiedzili Katedrę Anatomii i Neurobiologii oraz Klinikę Chirurgii Onkologicznej.
Dr hab. Sławomir Wójcik z Zakładu Anatomii i Neurobiologii, pełniący również funkcję kierownika Działu Rekrutacji GUMed, przygotował dla licealistów zajęcia warsztatowe w pracowniach anatomicznych. Rozpoczął je od pracy z klasycznymi preparatami. Była to m.in. okazja do zaawansowanej powtórki z neuroanatomii, mogącej przydać się zwłaszcza tej części uczestników, przed którymi w najbliższych dniach pierwszy ważny egzamin, jakim jest matura. W dalszej części lekcji uczniowie poznali możliwości, jakie daje interaktywny stół anatomiczny wykorzystywany w trakcie zajęć ze studentami. Ostatnia część spotkania była poświęcona przybliżeniu oferty edukacyjnej Uczelni oraz omówieniu procesu i warunków rekrutacji.

zajęcia z anatomii z dr. hab. Sławomirem Wójcikiem
Kolejnego dnia dr hab. Karol Połom z Katedry i Kliniki Chirurgii Onkologicznej zastanawiał się z uczestnikami nad przyszłością chirurgii. Opowiedział im o najnowszych narzędziach i kierunkach rozwoju tej gałęzi medycyny, zwracając jednocześnie uwagę na to, jak dynamicznym przemianom ona obecnie podlega. Nawiązując m.in. do coraz szerszego wykorzystania sztucznej inteligencji, zwrócił również uwagę na to, jak duże wyzwania i jak dużą odpowiedzialność nakłada to na lekarzy i naukowców. Część spotkania poświęcił roli i zastosowaniu mediów społecznościowych w szeroko rozumianej komunikacji naukowej oraz upowszechnianiu wiedzy naukowej. Na przykładzie wybranych wydarzeń, badań i publikacji zaprezentował uczestnikom korzyści wynikające z nowych możliwości, którymi dysponujemy (szybkie dzielenie się wiedzą i docieranie do danych), z drugiej zaś strony zwrócił uwagę na to, że działalność w przestrzeni wirtualnej nie zwalnia z odpowiedzialności za słowa i konieczności weryfikacji informacji.

warsztaty chirurgiczne z dr. hab. Karolem Połomem i lek. Marcinem Ekmanem
Po części wykładowej przyszedł czas na zajęcia praktyczne. Pod opieką dr. hab. Karola Połoma i lek. Marcina Ekmana z Katedry i Kliniki Chirurgii Onkologicznej uczestnicy zapoznali się z podstawowymi technikami i narzędziami chirurgicznymi, a następnie z sukcesem ćwiczyli zakładanie pierwszych szwów. Po więcej informacji na temat programu zapraszamy na stronę www.naukatoludzie.gumed.edu.pl.
fot. dr n. społ. Agnieszka Anielska/GUMed
Archiwum
- Rok akademicki 2024/2025
- Rok akademicki 2023/2024
- Rok akademicki 2022/2023
- Rok akademicki 2021/2022
- Rok akademicki 2020/2021
- Rok akademicki 2019/2020
- Rok akademicki 2018/2019
- Rok akademicki 2017/2018
- Rok akademicki 2016/2017
- Rok akademicki 2015/2016
- Rok akademicki 2014/2015
- Rok akademicki 2013/2014
- Rok akademicki 2012/2013
- Rok akademicki 2011/2012
- Rok akademicki 2010/2011
- Rok akademicki 2009/2010
- Rok akademicki 2008/2009
- Rok akademicki 2007/2008
- Inauguracje roku akademickiego